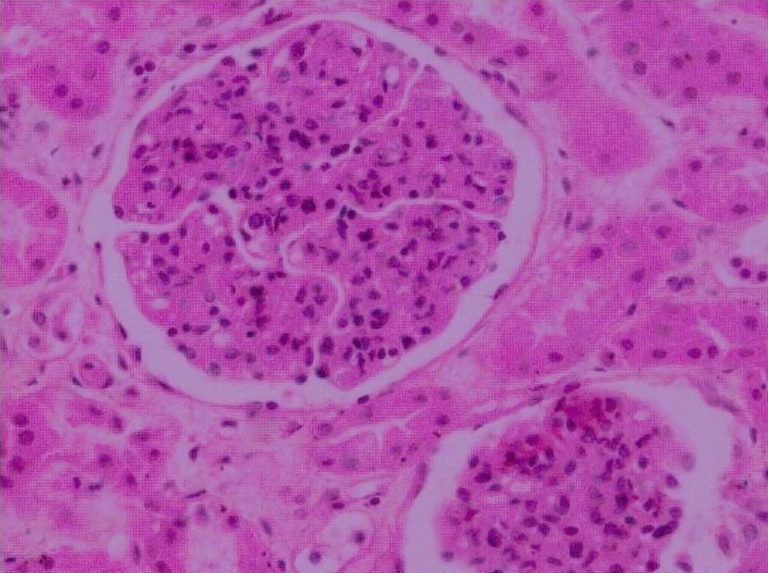
肾盂肾炎动物模型  泌尿系统模型

万千商家帮你免费找货
0 人在求购买到急需产品
- 详细信息
- 文献和实验
- 技术资料
- 提供商:
XSL
- 服务名称:
肾盂肾炎动物模型 泌尿系统模型
实验方法
利用倾斜平板法制备100000000/ml及1000000/ml两种浓度大肠埃希菌(O111B4)菌液待用,使用前测集落形成单位(CFU)值 核实浓度。体重200g左右雄性大鼠,术前常规禁水24h,先用细线扎住大鼠阴茎。在乙mi吸入麻醉下,动物仰卧固定于手术 板上,常规消毒腹部皮肤并去毛,沿下腹部正中切开,充分暴露左侧输尿管及膀胱,在输尿管中段用10号半圆针、0号黑线 向侧腹部穿针,暂不结扎。用注射器向膀胱内注射100000000/ml浓度的菌液,每只注射量约0.5ml左右,常规手术关闭腹 腔。以适度松紧结扎侧腹部黑线(24h后解除),松开扎住阴茎的细线,术后恢复正常饮水与进食。分别于实验预定时间作肾 功能及血生化指标测定;同时麻醉处死动物,取两侧肾脏,一半组织经固定液固定,作常规组织切片,光镜下病理检查;另 一半组织匀浆后作细菌培养。处死动物前膀胱穿刺抽取尿液作细菌培养。
模型特点
模型动物术后90d时,均表现为尿N-乙酰-β-D-氨基葡萄糖苷酶(NAG)/尿肌酐明显升高;模型制作过程中,24h尿蛋白定量无 明显增加。血肌酐(SCr)、尿素氮(BUN)分别于30、60、90d检测无明显升高。术后第7日时,模型动物膀胱尿标本及左肾组 织细菌培养为阳性,麦康凯培养基上为不透明红色圆形菌落,血平板上则为稍凸、中等大小、边缘整齐、不透明灰白色圆形 菌落;镜下为革兰氏染色阴性的粗短杆菌。细菌培养高阳性率可持续保持到术后第60日。肉眼观察第7日时模型动物左侧肾 脏明显肿大,其表面可见粟粒样脓肿,部分已融合成片;肾纵切面有脓肿形成;第15日时肾纵切面可见较多脓液,肾孟明显 扩张;第30日时肾脏肿胀部分减轻,外观仍见脓肿;第60日肾脏体积肿大减轻;第90日时左肾可见明显皮质瘢痕形成,表 面凹凸不平,体积缩小。肉眼观察未见右。肾有化脓灶或瘢痕形成,但可见右肾代偿性增大。镜下病理学观察显示,病变急 性期左肾肾盂黏膜上皮细胞坏死、脱落,腔内积脓,肾实质弥漫性化脓灶,小管腔内可见白细胞管型;7~15d时淋巴细胞 浸润明显;30d可见间质纤维组织增生,肾盂处瘢痕形成;60d时部分肾小球出现纤维化;90d时可见间质纤维化,并有灶性淋巴细胞浸润。

急性肾盂肾炎动物模型
单纯感染模型
实验方法
体重为200g左右大鼠,禁止饮水24h后,事先用细线扎住大鼠阴茎。在乙mi吸入麻醉下,动物仰卧固定手术板上,常规消毒 腹部皮肤并去毛,沿动物下腹部作正中剪开,充分暴露膀胱,用注射器直接向膀胱内一次性注射浓度为1000000/ml的大肠 埃希菌(O111B4)菌液,每只注射量约0.5ml,手术缝合切口,关闭腹腔。1h后松开扎阴茎细线。术后恢复动物正常饮水与进 食。分别于预定时间处死动物,取其两侧肾脏,小心去除肾包膜;然后纵向切开肾脏,一半匀浆后行细菌培养,另一半置于 固定液中固定,作常规组织切片,HE染色,光镜下观察。同期膀胱穿刺作尿液细菌培养。
模型特点
术后3d尿液能培养出细菌,于麦康凯培养基上生长出红色圆形菌落;至7d时仍有80%的动物细菌培养阳性,15d时则仅有少 数动物细菌培养阳性。肾组织细菌培养大部分动物双肾细菌培养为阳性,部分动物为一侧肾脏培养阳性。至第15日时,仍有 少数肾脏细菌培养阳性。大体标本肉眼观察可见模型动物双肾体积均有不同程度增大,肾表面无明显脓肿;其纵切面可见肾 盂扩张,黏膜充血,肾皮质、髓质分界不清。镜下病理学观察显示,3d时肾盂黏膜下及间质区以中性粒细胞为主伴有少量淋 巴细胞的炎症细胞浸润,毛细血管扩张、充血,间质水肿。第7日时肾盂黏膜下及间质内可见淋巴细胞灶性浸润,并可见少 量嗜酸性粒细胞,间质毛细血管扩张;至15d时仍可见间质淋巴细胞浸润,毛细血管增生、扩张,并有少量纤维母细胞、肉 芽组织形成。
手术+感染模型
实验方法
大肠埃希菌(O111B4)菌液的制备:将菌种接种于肉汤培养基,37℃、5%CO2孵箱内孵育12h,利用倾斜平板法制备 1000000/ml浓度菌液待用。体重为200g左右雄性大鼠,禁止饮水18h后经腹腔按30mg/kg体重剂量注射戊巴bi妥钠麻醉。动 物仰卧固定手术板上,常规消毒腹部皮肤并去毛,铺无菌手术巾。沿下腹部作长约2cm正中切口,逐层切开腹壁进入腹腔, 充分暴露左侧输尿管及膀胱;用4号缝合丝线从中段输尿管两旁分别向侧腹部穿针并引出缝合线,两针尽量保持相近,暂不 结扎,用动脉夹夹闭阴茎,用 TB针向膀胱内缓慢注入0.75ml菌液。然后拉紧腹壁外面的缝合线两端,以适当松紧度“结扎” 输尿管。逐层缝合腹壁切口,松开阴茎动脉夹,术后动物恢复常规饲养,自由饮水和进食。手术后20h,拆去腹壁外面输尿 管结扎线,使输尿管重新开放。分别在规定的时间用动脉夹夹住大鼠阴茎后,用乙mi麻醉,仰卧于手术台上,无菌条件下开 胸、开腹,抽出心血和尿液,切取左右肾脏和脾脏,作肉眼检查、细菌培养及病理组织学检查。
模型特点
术后第3日模型动物膀胱尿液即能培养出细菌,于麦康凯培养基上生长出红色圆形菌落。第7日时细菌培养阳性率分别可高达 80%以上,这种高阳性率可持续保持15d以上。结扎一侧肾脏肾组织细菌培养也有细菌生长,未结扎一侧肾脏细菌培养阳性 少见,且持续时间较短。心血和脾脏细菌培养均为阴性。肉眼观察模型动物左肾体积较右肾有不同程度增大,左肾表面可见 数量不等的微小脓肿,个别肾脏有突出肾表面的较大脓肿;切面肾盂扩大,黏膜充血、肿胀,肾盂内有脓性分泌物,有的肾 切面可见微小脓肿或锥形炎症灶。右肾外观和切面未见明显异常。镜下病理观察显示,术后3d模型动物左肾肾盂肾盏黏膜充 血肿胀,有的可见黏膜表面有局灶性脓性分泌物,黏膜下可见大量中性粒细胞浸润。肾间质血管充血,多数肾脏可见脓肿, 在一些肾乳头部尚可见大小不一的锥形炎症灶;肾小管不同程度扩张,以远曲小管为重;小管周围有较多中性粒细胞浸润, 部分肾小管上皮细胞坏死、脱落,管腔内可见脓细胞及少量管型。肾小球无明显损伤。术后7d动物左肾间质炎症细胞减少, 肾盂黏膜下、肾小管周围可见以中性粒细胞为主,伴有较多淋巴细胞和单核细胞的炎症细胞浸润;脓肿灶边缘出现较多成纤 维细胞,灶内除有中性粒白细胞外,尚有大量淋巴细胞、单核细胞。肾盂黏膜充血肿胀减轻,黏膜下中性粒细胞细胞浸润明 显减少,出现较多单核细胞、淋巴细胞。右肾组织无明显组织形态学改变。
需确认的信息
1. 模型种属(大鼠还是小鼠或是其他种属)
2. 动物体重有无要求,年龄有无要求
3. 雌雄有无要求
4. 模型构建具体方案
5. 取材要求(采血、取组织样本)
风险提示:丁香通仅作为第三方平台,为商家信息发布提供平台空间。用户咨询产品时请注意保护个人信息及财产安全,合理判断,谨慎选购商品,商家和用户对交易行为负责。对于医疗器械类产品,请先查证核实企业经营资质和医疗器械产品注册证情况。
 文献和实验
文献和实验知识,提高公众对乳腺癌的关注。 图 1. 2020 年全球范围乳腺癌年龄标准化发病率预估 动物模型是疾病研究及治疗方法探索中必不可少的工具,一个理想的乳腺癌动物模型应与人乳腺癌的肿瘤分子特性及生物行为学等方面存在共性,以便于发病机制的研究及治疗新药的开发。但从癌症的分型来看,单一的动物模型对乳腺癌表型模拟程度有限,因此在实际研究中还需结合具体需求选择合适的动物模型,才能更好地达到研究目的。接下来小编将带大家一起了解一下不同的乳腺癌模型特点及如何选择合适的模型。 乳腺癌动物模型主流的乳腺癌小鼠模型
癌症已经成为影响人类健康的重要疾病,发病率呈现逐年上升趋势,癌症研究领域中公认的缺陷之一是缺乏能够研究癌变和癌症治疗的模型系统。在过去的几十年中,抗肿瘤治疗药物的研发呈现爆炸式的增长,但是绝大多数新疗法都不能顺利通过III期临床试验,其主要原因就是缺乏合适的体内模型。我们常用的人类肿瘤细胞系或患者源性肿瘤移植到免疫缺陷小鼠体内的肿瘤动物模型,使用人类肿瘤细胞系建立的动物模型称作肿瘤细胞系异种移植模型(Cancer cell line-based xenograft , CDX),而使
jchent 有意研究wnt信号通路,但是生手不知如何下手。看到一篇文献做的是鸟的wnt相关基因表达,我想换一种动物模型,比如将鸟换成小鼠,将来可以比较二者的不同。不确定这是否可算作是科研创新?意义大吗?非常感谢!! qingguyouquan 我认为不算科研创新,是跟在别人后面走而已。不过也可以了,如果结果好的话毕业时没问题的。严格意义上的创新基本上是别人没怎么做或者没怎么涉及的,而你从另一个角度独辟蹊径,取得了一定成果
 技术资料
技术资料暂无技术资料 索取技术资料










